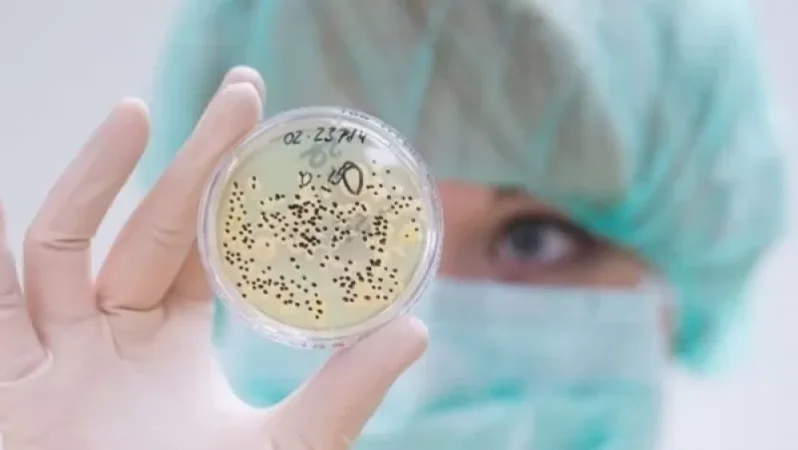
Ի՞նչ է իրենից ներկայացնում «սև բորբոս» սնկային հիվանդությունը

Ի՞նչ է իրենից ներկայացնում «սև բորբոս» սնկային հիվանդությունը
Մայիսի 19-ի դրությամբ` Հնդկաստանի մի քանի նահանգում հայտարարվել է մուկորմիկոզի համաճարակ: Դեպքերի թիվն անընդհատ աճում է՝ հիմնականում ախտահարելով Covid-19-ից բուժված անձանց: Բացի Հնդկաստանից, կորոնավիրուսային հիվանդության բռնկումից ի վեր, մուկորմիկոզի դեպքեր արձանագրվել են նաև Եգիպտոսում, Պակիստանում, Իրաքում, Չիլիում, Ուրուգվայում, Մեքսիկայում, Բրազիլիայում, Նեպալում, ՌԴ-ում:
Մուկորմիկոզը կամ «սև բորբոսը» հազվադեպ հանդիպող սնկային հիվանդություն է, որն առաջացնում է քթի, նշիկների, մաշկի նեկրոտիկ ախտահարում, կենտրոնական նյարդային համակարգի խանգարում: Մուկորմիկոզի ախտանշաններն են բարձր ջերմություն, հազ, գլխացավ, կոկորդի ցավ, քթային արտադրություն, աչքերի ցավ, խոց: Մուկորմիկոզի սնկերը հանդիպում են հողում, բույսերի, քայքայված մրգերի և բանջարեղենների վրա, ինչպես նաև կենդանիների արտաթորանքում, որոնք շնչառական համակարգով կամ արյան միջոցով ներթափանցում են օրգանիզմ:
Հիվանդությունից մահացության մակարդակը հասնում է մինչև 50%-ի: Մուկորմիկոզը հաճախ ախտահարում է ցածր իմունային համակարգ ունեցող անձանց, մասնավորապես` շաքարային դիաբետ, ստերոիդներ կամ երկաթ պարունակող դեղորայք ընդունող անձանց:







